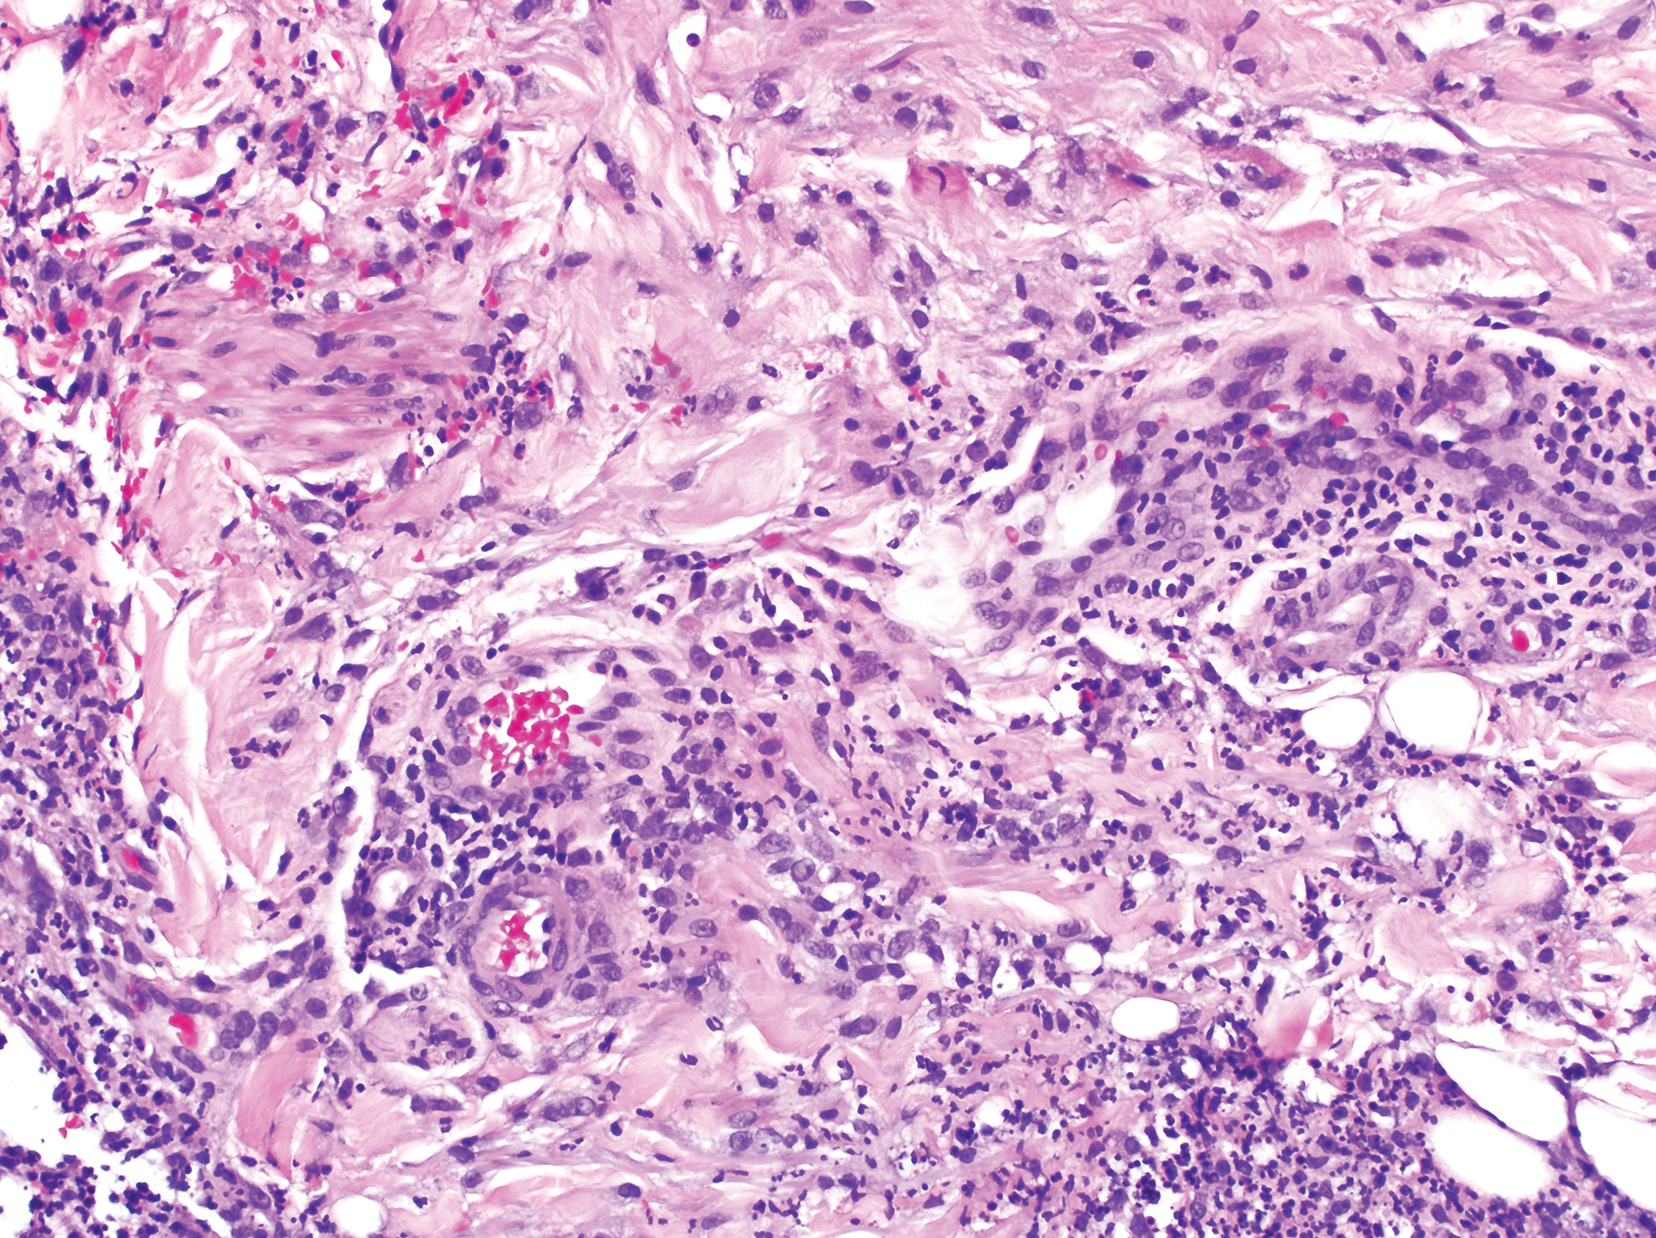

Case Report
A 79-year-old man with chronic lymphocytic leukemia (CLL) who was being treated with ibrutinib presented to the emergency department with a dry cough, ataxia and falls, and vision loss. Physical examination was remarkable for diffuse crackles heard throughout the right lung and bilateral lower extremity weakness. Additionally, he had 4 pink mobile nodules on the left side of the forehead, right side of the chin, left submental area, and left postauricular scalp, which arose approximately 2 weeks prior to presentation. The left postauricular lesion had been tender at times and had developed a crust. The cutaneous lesions were all smaller than 2 cm.
The patient had a history of squamous cell carcinoma of the skin and was under the care of a dermatologist as an outpatient. His dermatologist had described him as an active gardener; he was noted to have healing abrasions on the forearms due to gardening raspberry bushes.
Computed tomography of the head revealed a 14-mm, ring-enhancing lesion in the left paramedian posterior frontal lobe with surrounding white matter vasogenic edema (Figure 1). Computed tomography of the chest revealed a peripheral mass on the right upper lobe measuring 6.3 cm at its greatest dimension (Figure 2).
Empiric antibiotic therapy with vancomycin and piperacillin-tazobactam was initiated. A dermatology consultation was placed by the hospitalist service; the consulting dermatologist noted that the patient had subepidermal nodules on the anterior thigh and abdomen, of which the patient had not been aware.
Clinically, the constellation of symptoms was thought to represent an infectious process or less likely metastatic malignancy. Biopsies of the nodule on the right side of the chin were performed and sent for culture and histologic examination. Sections from the anterior right chin showed compact orthokeratosis overlying a slightly spongiotic epidermis (Figure 3). Within the deep dermis, there was a dense mixed inflammatory infiltrate comprising predominantly neutrophils, with occasional eosinophils, lymphocytes, and histiocytes (Figure 4).